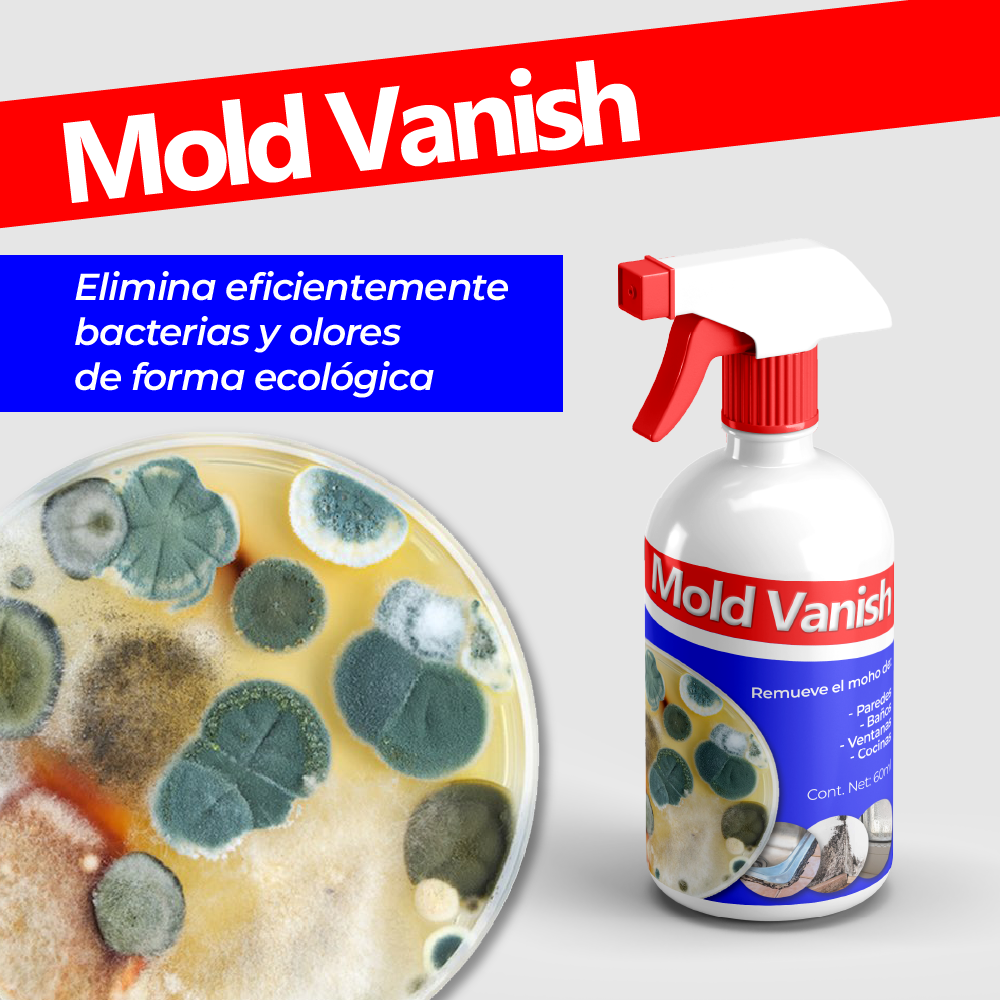

MoldVanish™ - removedor de moho de múltiples superficies
MoldVanish™ - removedor de moho de múltiples superficies



¡Lleva más y ahorra!
¡Últimas unidades disponibles!
No se pudo cargar la disponibilidad de retiro


MoldVanish™ - removedor de moho de múltiples superficies
¡STOCK LIMITADO! - ÚLTIMAS UNIDADES
MANTEN LA HIGIENE DE TU HOGAR Y ELIMINA EL MOHO AL INSTANTE
Experimenta la revolución en la limpieza con este increíble removedor de moho de alto rendimiento. Su formula esta diseñada para eliminar hasta las manchas de moho más persistentes. siendo esta la solución definitiva para restaurar la frescura y la limpieza en tus espacios.
DILE ADIÓS AL MOHO EN LAS PAREDES, BAÑOS Y OTRAS AREAS
Este producto ofrece una protección duradera contra su la reaparición del moho en todos tus espacios. Su fórmula crea una barrera protectora que impide que el moho vuelva a crecer en las áreas tratadas, brindándote tranquilidad y una sensación de frescura duradera en tu hogar.
PROTEGE TUS SUPERFICIES Y A TU FAMILIA
Gracias a MoldVanish™ no solo obtendrás una limpieza profunda y duradera, sino que también mantendrás la integridad de tus superficies, prolongando su vida útil y manteniendo la estética de tu hogar. Además, esta formula es amigable con la piel, por lo que tampoco tendrás que preocuparte por intoxicaciones no deseadas.
ESPECIFICACIONES
Cont. Net: 60ml